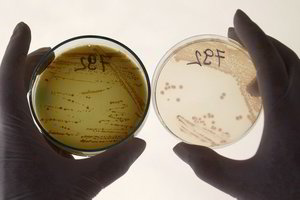
E.coli bakterija gali slėptis geriamajame vandenyje

Clemsono universiteto (JAV) profesorius Paulas Dawsonas papasakojo, kaip yra iš tiesų.
Nors penkių sekundžių taisyklė maistą tyrinėjantiems mokslininkams gali pasirodyti ne pirmo svarbumo problema, tačiau vis tiek verta ištirti tokius, kaip šis, mitus apie maistą, nes jie formuoja mūsų įsitikinimus, kada maistas yra saugus valgyti.
Taigi – ar penkios sekundės ant grindų yra kritinė riba, skirianti valgomą maistą nuo to, kuriuo galima apsinuodyti?
Tai šiek tiek sudėtingesnis dalykas nei atrodo – viskas priklauso nuo to, kiek bakterijų per kelias sekundes gali patekti ant maisto ir nuo to, kiek purvinos yra grindys.
Iš kur kilo penkių sekundžių taisyklė?
Gana dažnas yra svarstęs, ar maistas tinkamas valgyti po to, kai jis buvo nukritęs ant grindų (ar kito paviršiaus).
Manoma, kad prie šio mito atsiradimo galėjo prisidėti gerai žinoma, tačiau netiksli istorija apie legendinę JAV kulinarinių laidų vedėją Julią Child.
Kai kurie jos kulinarinės laidos „The French Chef“ žiūrovai tvirtina, kad jie pamatė, kaip vaikui iš rankų iškrito gabalėlis ėrienos (arba vištienos, ar kalakutienos, atsižvelgiant į istorijos versiją) ant grindų, ir jį berniukas pakėlė sakydamas: jei jie būtų virtuvėje vieni, svečiai niekada to nesužinotų.

L.Gilbert (Wikipedia.com) nuotr.
Tiesą sakant, tai buvo bulvinis blynas ir jis nukrito ant viryklės, o ne ant grindų. Vaikas padėjo jį atgal į keptuvę sakydamas: „Jūs visada galite jį paimti, o jei virtuvėje esate vienas, kas tai pamatys?“
Sunkiau nustatyti dažnai linksniuojamos penkių sekundžių taisyklės kilmę, tačiau 2003 m. atliktas tyrimas parodė, kad 70 proc. apklaustų moterų ir 56 proc. vyrų buvo susipažinę su penkių sekundžių taisykle ir kad moterys labiau nei vyrai yra linkusios valgyti tai, kas buvo nukritę ant grindų.
Taigi, ką mums sako mokslas apie tai, ar galima valgyti maistą, kuris buvo nukritęs ant žemės kelioms sekundėms?
Penkios sekundės
Anksčiausia tyrimų, susijusių su penkių sekundžių taisykle, ataskaita priskiriama Jillianui Clarke'ui, vidurinės mokyklos moksleiviui, dalyvavusiam tyrime Ilinojaus universitete. J.Clarke'as ir jo kolegos padengė grindų plyteles bakterijomis, tada padėdavo ant jų maisto ir palikdavo tam tikram laiko tarpui.

123rf nuotr.
Paaiškėjo, kad bakterijos nuo plytelių ant sausainių patekdavo per penkias sekundes, tačiau mokslininkai nepranešė apie konkretų bakterijų kiekį, kuris patekdavo ant maisto.
Taigi, kiek bakterijų ant maisto iš tikrųjų patenka per penkias sekundes?
2007 m. Klemsono universiteto mokslininkai paskelbė tyrimo rezultatus žurnale „Applied Microbiology“ – vienintelį recenzuojamą žurnalo pranešimą šia tema. Norėta sužinoti, ar laikas, per kurį maistas liečiasi su užterštu paviršiumi, paveikia bakterijų patekimo į maistą greitį.
Norėdami tai sužinoti, turėjai paskleidė ant plytelių, kilimo ar medžio salmonelių. Tuomet penkioms, trisdešimčiai ir šešiasdešimčiai sekundžių padėjo duonos ant šio paviršiaus ir vėliau išmatavo bakterijų kiekį duonoje. Šią tikslią seką pakartojo ir aiškindamiesi, kiek bakterijų susikaupė ant dvi, keturias, aštuonias ir 24 valandas išgulėjusios duonos paviršiaus.
Pasirodo, kad bakterijų kiekis mažai priklausė nuo to, kiek laiko maistas turėjo kontaktą su užterštu paviršiumi – ar kelias sekundes, ar visą minutę.
Įtakos turi ir paviršius, ant kurio nukrenta maistas. Pavyzdžiui, kilimai, atrodo, yra šiek tiek geresnė vieta maistui nukristi nei mediena ar plytelės.
Ant salmonelėmis užkrėsto kilimo nukritusiame maiste rasta mažiau nei 1 proc. bakterijų. Bet kai maistas lietėsi su plytelėmis ar medžiu, 48–70 proc. bakterijų pateko į maistą.
Praėjusiais metais Astono universiteto (JK) atliktas tyrimas buvo beveik identiškas, ir rezultatai buvo panašūs.
Ar galime valgyti maistą, kuris nukrito ant grindų?
Maisto saugos požiūriu, jei ant kokio nors paviršiaus yra milijonai bakterijų, vis viena pakanka 0,1 proc., kad jūs užsikrėstumėte ir jus pradėtų pykinti.
Be to, tam tikros rūšies bakterijos turi itin stiprią savybę užkrėsti, ir užteks nedidelio jų kiekio, kad jus susargdintų. Pavyzdžiui, 10 ar mažiau lengvai plintančių E. coli bakterijų gali sukelti sunkią ligą ir mirtį žmonėms, kurių silpna imuninė sistema. Tačiau šių bakterijų tikimybė atsirasti ant paviršių yra labai mažai tikėtina.
Susiję straipsniai
Maistą užteršti bakterijomis galite ne tik tada, kai netyčia jį numetate ant grindų. Bakterijų gausu įvairiose vietose, kur gaminamas maistas, ant drėgnų paviršių, kurios liečiamos rankomis, kur kosima, čiaudima.
Ant rankų, maisto ir indų gali būti skirtingų bakterijų. Taigi, kai kitą kartą svarstysite, ar valgyti maistą, nukritusį ant žemės, jums gali pasisekti – nesusirgsite. Tačiau retais atvejais ant žemės gali būti mikroorganizmų, galinčių jus susargdinti.
Tyrimai (ir sveikas protas) mums sako, kad geriausia visur palaikyti švarą.
Parengta pagal theconversation.com